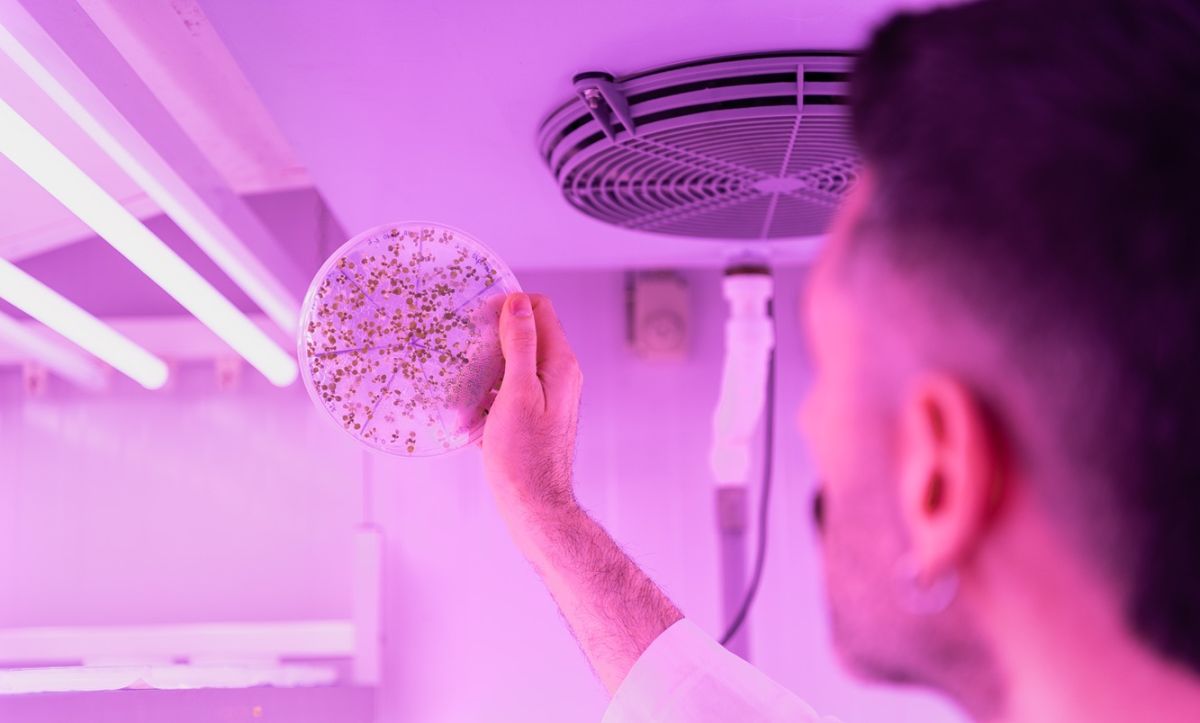

Ciencia
Hallan un ‘interruptor molecular’ que controla cómo las plantas forman sus vasos conductores
- Gracias a un consorcio internacional con participación del Instituto de Biología Molecular y Celular de Plantas
El texto se ha copiado correctamente en el portapapeles
Un equipo internacional de investigadores, en el que ha participado el Instituto de Biología Molecular y Celular de Plantas (Ibmcp), centro mixto del Consejo Superior de investigaciones científicas (CSIC) y la Universidad Politécnica de Valencia (UPV), ha descubierto un nuevo mecanismo molecular que regula cómo se forman los tejidos vasculares en las plantas.
El estudio, publicado en la revista ‘Science’, revela de qué manera una pequeña molécula llamada termoespermina puede actuar como un interruptor biológico y controlar la producción de proteínas clave para el desarrollo del xilema, el tejido que transporta agua y aporta soporte estructural a las plantas.
El trabajo demuestra que esta regulación solo es posible cuando los ribosomas -las estructuras celulares encargadas de fabricar proteínas- presentan una modificación química específica en su ARN catalizada por la enzima OVAC. Este hallazgo abre una nueva perspectiva sobre cómo las plantas controlan su desarrollo a nivel molecular.
“Aunque se trata principalmente de investigación básica, entender cómo se regula la formación de tejidos vasculares podría tener implicaciones a largo plazo en agricultura y biotecnología vegetal”, apunta Miguel Ángel Blázquez, investigador del Ibmcp y coautor del estudio.
Blázquez apunta: “Los mecanismos descritos podrían contribuir en el futuro a estrategias para ajustar el desarrollo del xilema y, por tanto, influir en características relevantes de los cultivos, como la formación de raíces u órganos de almacenamiento, la eficiencia en el transporte de agua o la producción de biomasa y madera”.
SENSOR
El trabajo ha permitido demostrar experimentalmente que la actividad de la termoespermina depende de la modificación química del ribosoma. Para ello, los investigadores utilizaron un sistema de análisis de eficiencia traduccional en protoplastos de ‘Arabidopsis’, planta modelo muy utilizada en investigación.
“Nuestros experimentos constataron que la termoespermina solo puede regular la producción de dos factores clave del desarrollo vascular -SACL y LHW- cuando los ribosomas están previamente metilados por la enzima OVAC. El equilibrio entre estas dos proteínas es fundamental, ya que determina el destino de las células vasculares: si se diferencian en vasos conductores de agua o en células de almacenamiento”, añade Alejandro Ferrando, del Ibmcp y coautor del estudio.
El estudio aporta un nuevo concepto en biología molecular vegetal: el ribosoma no actúa únicamente como una ‘máquina de síntesis de proteínas’, sino que su composición química puede convertirlo en un sensor que integra señales metabólicas y regula la traducción de genes específicos.
(SERVIMEDIA)
02 Abr 2026
MGR/clc



